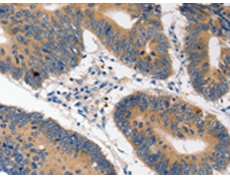
一抗

抗 原: HDC
標 記 物: Unconjugate
技術(shù)規(guī)格
|
Background: |
This gene encodes a member of the group II decarboxylase family and forms a homodimer that converts L-histidine to histamine in a pyridoxal phosphate dependent manner. Histamine regulates several physiologic processes, including neurotransmission, gastric acid secretion,inflamation, and smooth muscle tone. |
|
Applications: |
ELISA, IHC |
|
Name of antibody: |
HDC |
|
Immunogen: |
Fusion protein of human HDC |
|
Full name: |
histidine decarboxylase |
|
SwissProt: |
P19113 |
|
ELISA Recommended dilution: |
1000-5000 |
|
IHC positive control: |
Human colon cancer and Human ovarian cancer |
|
IHC Recommend dilution: |
5-20 |


 購物車
購物車 幫助
幫助
 021-54845833/15800441009
021-54845833/15800441009